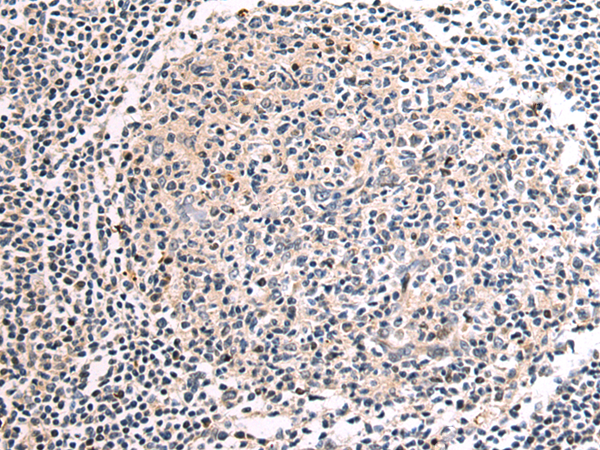

-
分类: 科研抗体货号: P10113别名: EIF2B; EIF-2Bbeta应用: IHC反应种属: Human, Mouse, Rat
-
分类: 科研抗体货号: P10090别名: RPC6; RPC39应用: WB,IHC反应种属: Human, Mouse, Rat
-
分类: 科研抗体货号: P10112别名: PUS4应用: IHC反应种属: Human, Mouse, Rat
-
分类: 科研抗体货号: P10089别名: ATPQ; ATP5H应用: WB,IHC反应种属: Human, Mouse
-
分类: 科研抗体货号: P10105别名: REGH; REGL; PSPS2; REGI-BETA应用: WB,IHC反应种属: Human
-
分类: 科研抗体货号: P10087别名: PNAA; PNAD应用: IHC反应种属: Human, Mouse
-
分类: 科研抗体货号: P10102别名: PFE; PTHR; PTHR1应用: IHC反应种属: Human, Mouse, Rat
-
分类: 科研抗体货号: P10086别名: NAPRT1; PP3856应用: IHC反应种属: Human
-
分类: 科研抗体货号: P10101别名:应用: WB,IHC反应种属: Human
-
分类: 科研抗体货号: P10085别名: HOT1; PBHNF; HNF1LA应用: WB,IHC反应种属: Human, Mouse

鄂公网安备42018502007531号
鄂公网安备42018502007531号

